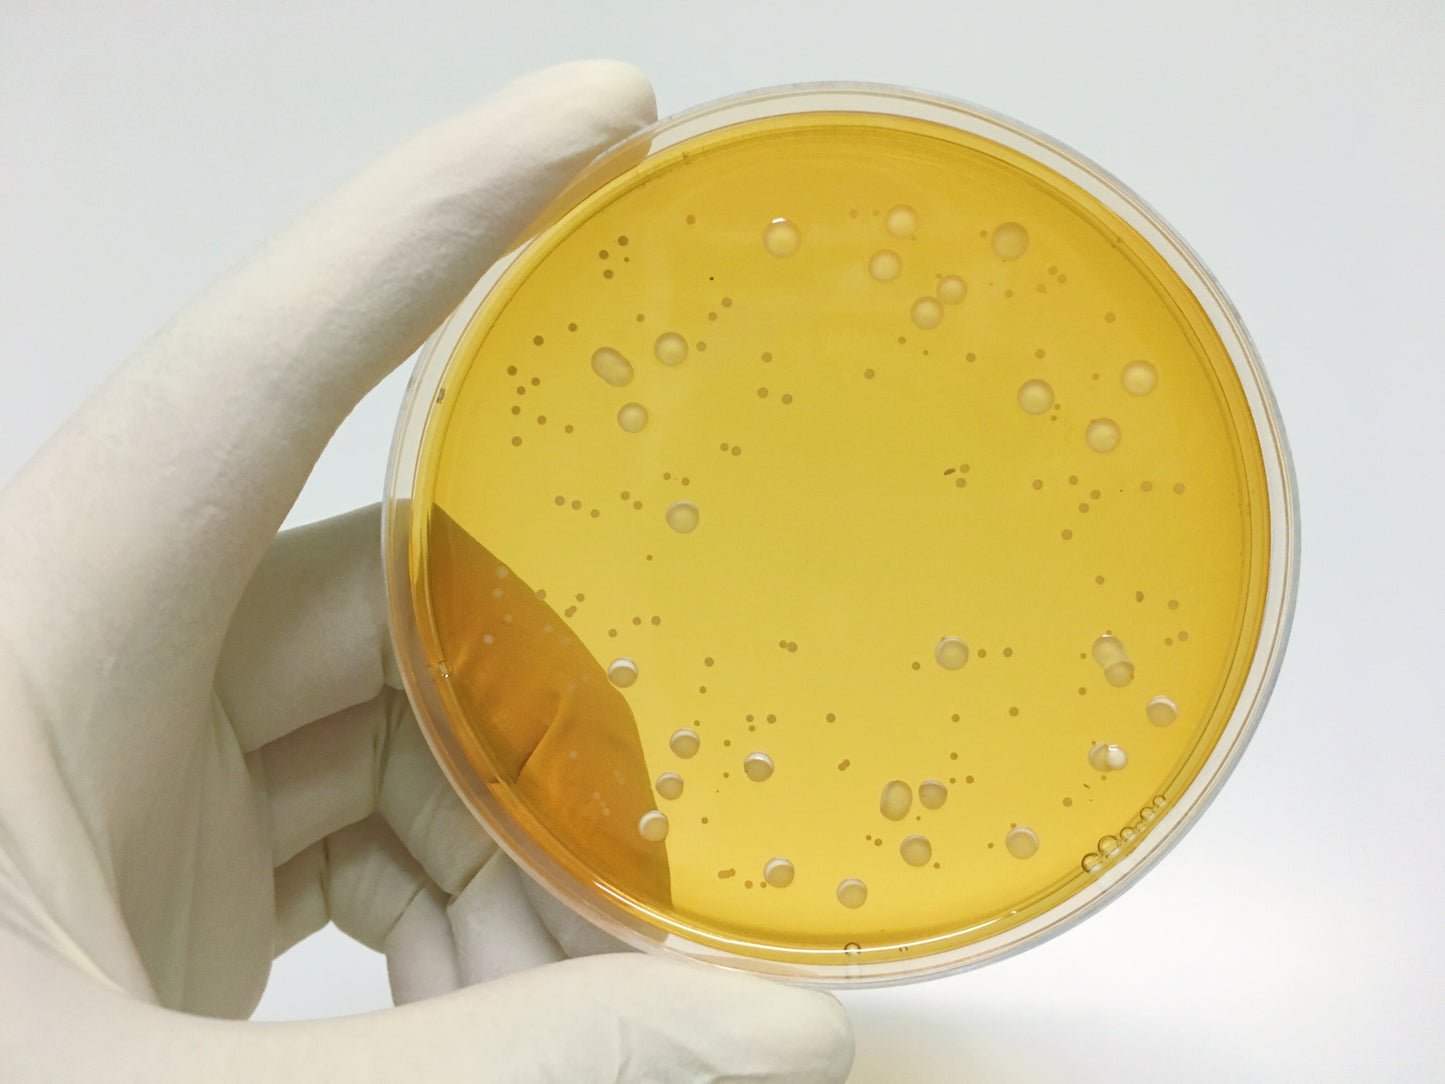

1
/
de
1
Microbiologie du lait et des produits laitiers
Microbiologie du lait et des produits laitiers
- Notions générales de la microbiologie
- Types de microorganismes
- Facteurs de croissance des microorganismes
- Impacts des microorganismes sur la transformation et la dégradation des produits laitiers